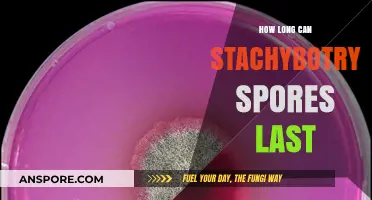
Stachybotrys Spores Lifespan: How Long Do They Survive in Your Home?

Black mold spores are microscopic particles released by mold colonies, particularly those of the species Stachybotrys chartarum, which can remain airborne for extended periods, often ranging from hours to days, depending on environmental conditions. Factors such as humidity, temperature, air circulation, and the presence of surfaces for spores to settle on significantly influence their airborne duration. Understanding how long black mold spores stay airborne is crucial, as prolonged exposure can pose serious health risks, including respiratory issues, allergies, and more severe complications for individuals with compromised immune systems. Effective mitigation strategies, such as improving ventilation, reducing moisture, and using air purifiers, can help minimize airborne spore concentrations and protect indoor air quality.
| Characteristics | Values |
|---|---|
| Time Airborne | Black mold spores can remain airborne for several hours to days. |
| Factors Affecting Airborne Time | Airflow, humidity, temperature, and spore size. |
| Settling Time | Most spores settle within 10 minutes to 1 hour in still air. |
| Survival in Air | Spores can survive in the air indefinitely under suitable conditions. |
| Re-suspension | Spores can become airborne again with disturbance (e.g., cleaning). |
| Health Risks | Prolonged exposure to airborne spores can cause respiratory issues. |
| Removal Methods | HEPA filters, air purifiers, and proper ventilation reduce airborne spores. |
| Environmental Persistence | Spores can persist in the environment for months to years if not removed. |
| Optimal Conditions for Survival | High humidity (above 70%), warm temperatures (25-30°C), and darkness. |
| Inactivation Methods | UV light, extreme temperatures, and antimicrobial treatments. |
Explore related products
What You'll Learn
- Factors Affecting Airborne Time: Humidity, temperature, ventilation, spore size, and air currents impact how long spores stay airborne
- Typical Airborne Duration: Black mold spores can remain airborne from a few hours to several days
- Health Risks of Inhalation: Prolonged exposure to airborne spores may cause respiratory issues, allergies, and other health problems
- Removal Methods: Air purifiers, HEPA filters, and professional remediation reduce airborne spore concentration effectively
- Prevention Strategies: Control moisture, fix leaks, and improve ventilation to prevent mold growth and airborne spores

Factors Affecting Airborne Time: Humidity, temperature, ventilation, spore size, and air currents impact how long spores stay airborne
Black mold spores can remain airborne for hours, days, or even weeks, depending on a complex interplay of environmental factors. Understanding these factors—humidity, temperature, ventilation, spore size, and air currents—is crucial for managing indoor air quality and minimizing exposure risks. Each element influences spore behavior in distinct ways, creating a dynamic system that dictates how long these microscopic particles stay suspended in the air.
Humidity and Temperature: The Dual Regulators
High humidity levels (above 60%) create an ideal environment for mold spores to thrive and remain airborne. Moisture in the air prevents spores from settling, allowing them to float indefinitely. Conversely, low humidity can cause spores to dry out and settle more quickly. Temperature also plays a pivotal role; warmer conditions (70–90°F) accelerate spore dispersal, while cooler temperatures slow their movement. For instance, in a damp, warm basement, spores may stay airborne for days, whereas in a dry, air-conditioned room, they might settle within hours. Practical tip: Maintain indoor humidity below 50% and keep temperatures moderate to discourage spore suspension.
Ventilation: The Invisible Force
Proper ventilation is a double-edged sword. On one hand, it can dilute spore concentration by introducing fresh outdoor air, reducing the time spores remain airborne. On the other, inadequate or poorly designed ventilation systems can recirculate spores, prolonging their airborne lifespan. For example, a poorly ventilated bathroom with a mold problem can trap spores in the air for extended periods, increasing exposure risk. To mitigate this, ensure HVAC systems are regularly maintained and use exhaust fans in high-moisture areas. Ideal ventilation rates for homes range from 0.35 to 0.5 air changes per hour (ACH) to balance air quality and energy efficiency.
Spore Size and Air Currents: The Microscopic Dance
Smaller mold spores (1–5 microns) can remain airborne longer than larger ones due to their lower settling velocity. For context, *Stachybotrys chartarum* (black mold) spores are typically 3–5 microns, allowing them to stay suspended for hours or even days in still air. Air currents, whether natural or mechanical, further complicate this dynamic. A gentle breeze or a running fan can keep spores aloft, while strong drafts may disperse them across larger areas. In a poorly sealed attic with a mold infestation, spores can travel through gaps and cracks, staying airborne as they move from one space to another. To minimize this, seal air leaks and use HEPA filters to capture airborne spores effectively.
Practical Takeaways for Control
To reduce the time black mold spores stay airborne, focus on controlling the factors within your reach. Invest in a dehumidifier to maintain optimal humidity levels, ensure consistent ventilation, and monitor indoor temperatures. Regularly clean and replace air filters, and address any mold sources promptly. For high-risk areas like basements or bathrooms, consider using air purifiers with HEPA filters to trap spores. By manipulating these environmental factors, you can significantly shorten the airborne lifespan of mold spores, safeguarding your indoor air quality and health.
Does Spore Work on Gholdengo? Exploring Pokémon Type Matchups
You may want to see also

Typical Airborne Duration: Black mold spores can remain airborne from a few hours to several days
Black mold spores, once airborne, can linger in the environment far longer than one might expect, typically remaining suspended from a few hours to several days. This duration is influenced by several factors, including humidity, temperature, and air circulation. In high-humidity environments, such as bathrooms or basements, spores can thrive and stay aloft for extended periods, posing a persistent health risk. Conversely, in dry conditions, they may settle more quickly, reducing their airborne lifespan but increasing the likelihood of surface contamination.
Understanding the airborne duration of black mold spores is crucial for effective remediation. For instance, during cleanup efforts, using air scrubbers with HEPA filters can significantly reduce spore counts in the air, but the process must account for their potential to remain airborne for days. This is particularly important in occupied spaces, where prolonged exposure can lead to respiratory issues, allergies, or more severe health complications, especially in vulnerable populations like children, the elderly, or those with compromised immune systems.
A comparative analysis reveals that black mold spores behave differently from other common allergens like pollen or dust mites. While pollen may remain airborne for weeks under certain conditions, black mold spores are heavier and tend to settle faster, though they can still circulate for days in stagnant air. This distinction highlights the need for targeted strategies, such as improving ventilation and reducing moisture, to minimize their airborne presence. Practical tips include running dehumidifiers in damp areas and regularly inspecting hidden spaces like crawlspaces or behind walls, where mold often thrives undetected.
From an instructive standpoint, homeowners and professionals alike should follow a systematic approach to manage airborne spores. First, identify and address the moisture source fueling mold growth. Second, isolate the affected area to prevent spore dispersal during cleanup. Third, use personal protective equipment, such as N95 masks, to avoid inhalation. Finally, monitor air quality post-remediation to ensure spore levels have returned to safe thresholds. Ignoring these steps can lead to recurrent mold problems, as spores that remain airborne can recolonize even after visible mold is removed.
In conclusion, the typical airborne duration of black mold spores—ranging from hours to days—underscores the need for proactive and informed management. By understanding the factors that influence their persistence and implementing targeted strategies, individuals can mitigate health risks and prevent long-term mold issues. This knowledge is not just theoretical but a practical tool for creating safer, healthier indoor environments.
Breathing Black Mold Spores: Lung Damage Risks and Prevention Tips
You may want to see also

Health Risks of Inhalation: Prolonged exposure to airborne spores may cause respiratory issues, allergies, and other health problems
Black mold spores can remain airborne for several hours to days, depending on environmental conditions such as humidity, temperature, and air circulation. During this time, they pose a significant health risk, particularly when inhaled over prolonged periods. The lightweight nature of these spores allows them to travel easily through indoor spaces, increasing the likelihood of exposure in homes or workplaces with mold infestations. Understanding the duration of their airborne presence underscores the urgency of addressing mold issues promptly to mitigate health risks.
Prolonged inhalation of black mold spores can lead to a range of respiratory issues, especially in vulnerable populations such as children, the elderly, and individuals with pre-existing conditions like asthma or chronic obstructive pulmonary disease (COPD). Symptoms may include persistent coughing, wheezing, and shortness of breath. For asthmatics, exposure can trigger severe attacks, while long-term exposure in healthy individuals may contribute to the development of respiratory conditions. Studies suggest that even low to moderate levels of mold spores in the air can exacerbate existing respiratory problems, emphasizing the need for air quality monitoring in mold-prone environments.
Allergic reactions are another common health risk associated with prolonged exposure to airborne black mold spores. Symptoms can range from mild, such as sneezing, runny nose, and skin rashes, to more severe reactions like conjunctivitis or difficulty breathing. Individuals with mold allergies may experience heightened sensitivity, reacting to even small concentrations of spores. Over time, repeated exposure can lead to chronic allergic responses, reducing overall quality of life. To minimize these risks, experts recommend using HEPA air filters and maintaining indoor humidity below 50% to discourage mold growth.
Beyond respiratory and allergic issues, prolonged inhalation of black mold spores has been linked to other health problems, including fatigue, headaches, and cognitive difficulties often referred to as "mold fog." While research is ongoing, some studies suggest that mycotoxins produced by black mold may contribute to systemic inflammation and immune system suppression. Pregnant individuals and those with compromised immune systems are particularly at risk. Practical steps to reduce exposure include regular inspection of damp areas, prompt repair of leaks, and professional mold remediation when necessary.
In conclusion, the health risks of inhaling black mold spores are both diverse and serious, particularly with prolonged exposure. From respiratory distress and allergies to potential systemic effects, the impact on health can be significant. Awareness of these risks, combined with proactive measures to control indoor mold growth and improve air quality, is essential for safeguarding well-being. If airborne spores are suspected, consulting with a healthcare provider and addressing the source of mold are critical steps to prevent long-term health complications.
Do Ferns Produce Spores or Seeds? Unraveling Their Unique Reproduction
You may want to see also
Explore related products
$16.95

Removal Methods: Air purifiers, HEPA filters, and professional remediation reduce airborne spore concentration effectively
Black mold spores can remain airborne for extended periods, posing health risks and complicating removal efforts. While their exact lifespan in the air depends on factors like humidity and airflow, reducing their concentration is critical for a safe environment. Air purifiers equipped with HEPA filters are a frontline defense, capturing particles as small as 0.3 microns with 99.97% efficiency. For optimal results, choose a unit sized for your room and run it continuously, ensuring at least 4-5 air changes per hour. This method is particularly effective in enclosed spaces where spores tend to accumulate.
Professional remediation takes spore removal a step further, addressing the source of mold growth while mitigating airborne spread. Certified technicians use containment barriers, negative air pressure systems, and industrial-grade HEPA filters to isolate and extract spores during cleanup. This process is essential for severe infestations, as DIY methods often disturb spores, increasing airborne levels. While costly, professional remediation ensures thorough removal and prevents recurrence, making it a long-term investment in air quality and health.
Comparing these methods reveals their complementary strengths. Air purifiers offer ongoing maintenance, ideal for preventing spore buildup in mold-prone areas like basements or bathrooms. HEPA filters in HVAC systems provide whole-home protection but require regular replacement every 6-12 months to maintain efficacy. Professional remediation, however, is a one-time solution for active infestations, though it may necessitate temporary relocation due to the intensity of the process. Combining these approaches creates a multi-layered strategy to minimize airborne spores effectively.
For those with respiratory sensitivities or compromised immune systems, proactive measures are non-negotiable. Place air purifiers in high-risk areas like bedrooms or living rooms, ensuring they’re positioned away from walls for maximum airflow. Pair this with routine inspections for mold growth, especially after water damage or in humid climates. While no method guarantees zero spores, consistent use of these tools significantly reduces exposure, creating a safer indoor environment. Remember, the goal isn’t just removal—it’s prevention.
Does Killz Upshot Effectively Eliminate Mold Spores? A Detailed Analysis
You may want to see also

Prevention Strategies: Control moisture, fix leaks, and improve ventilation to prevent mold growth and airborne spores
Black mold spores can remain airborne for extended periods, sometimes weeks, depending on environmental conditions. Their persistence underscores the critical need for proactive prevention strategies. Controlling moisture, fixing leaks, and improving ventilation are not just recommendations—they are essential practices to disrupt the mold lifecycle and safeguard indoor air quality.
Step 1: Control Moisture
Mold thrives in damp environments, making moisture control the cornerstone of prevention. Aim to maintain indoor humidity below 60%, ideally between 30% and 50%. Use dehumidifiers in high-moisture areas like basements, bathrooms, and kitchens. Regularly inspect for condensation on windows, pipes, or walls, as these are early indicators of excess moisture. Wipe down wet surfaces within 24–48 hours to prevent mold colonization. For larger areas, consider using moisture meters to identify hidden dampness behind walls or under floors.
Step 2: Fix Leaks Promptly
Even minor leaks can create conditions conducive to mold growth. Inspect plumbing fixtures, roofs, and foundations for signs of water intrusion. Repair leaks immediately, and replace water-damaged materials like drywall or insulation. In areas prone to flooding, elevate appliances and electrical systems above potential water levels. For persistent issues, consult a professional to address structural vulnerabilities or recurring plumbing problems.
Step 3: Improve Ventilation
Stagnant air traps moisture and allows spores to accumulate. Enhance airflow by using exhaust fans in bathrooms and kitchens, ensuring they vent to the outdoors. Open windows periodically to allow fresh air circulation, especially during humid seasons. In tightly sealed homes, consider installing a whole-house ventilation system to maintain consistent air exchange. For enclosed spaces like closets or storage areas, use portable fans or leave doors ajar to discourage mold-friendly conditions.
Cautions and Considerations
While implementing these strategies, avoid over-drying indoor air, as this can lead to other health issues like respiratory irritation. Balance dehumidification with adequate hydration. Be cautious when handling mold-infested materials—wear protective gear, including gloves, masks, and goggles, to avoid inhaling spores. If mold covers more than 10 square feet, professional remediation may be necessary to ensure thorough removal.
By controlling moisture, fixing leaks, and improving ventilation, you can significantly reduce the risk of mold growth and airborne spores. These measures not only protect your home but also enhance overall indoor air quality, promoting a healthier living environment. Consistency is key—regular maintenance and vigilance are far more effective than reactive measures once mold has taken hold.
Inoculating Mushroom Mycelium with Cold Spores: Risks and Best Practices
You may want to see also
Frequently asked questions
Black mold spores can stay airborne indefinitely, as they are lightweight and can float in the air until they settle on a surface or are removed by filtration or ventilation.
Yes, environmental factors like humidity, temperature, and air movement can influence how long black mold spores remain airborne. Higher humidity and stagnant air can prolong their airborne presence.
Yes, air purifiers with HEPA filters and well-maintained HVAC systems can effectively capture and remove black mold spores from the air, significantly reducing their airborne time.